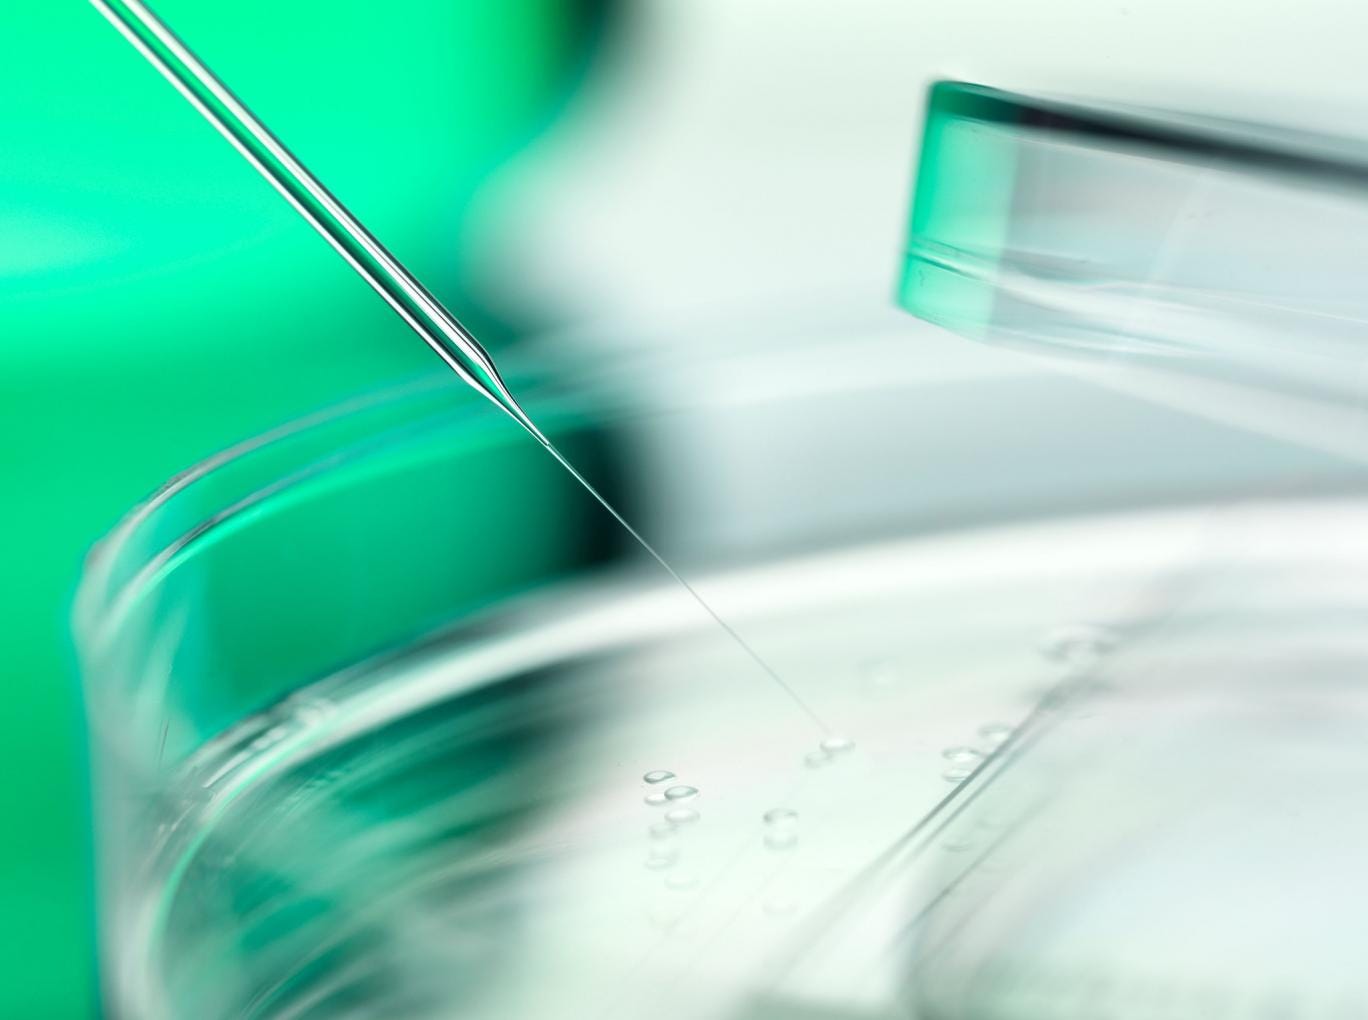

Lord Beaverbrook, the heir of his family’s famous newspaper empire, will join healthcare group Thorn Medical as chairman ahead of a planned £350m flotation later this year.
Lord Beaverbrook, the grandson of the man who founded the Daily Express, previously chaired a number of early stage ventures which were later sold to corporate giants IBM.
He was also Treasurer to the Conservative Party in the early 1990s and used to sit on the board of Thorn Medical as a non-executive.
He said: “I regretted having to leave Thorn Medical to devote my time to other matters, but am glad to be rejoining the board now in the run-up to our imminent stock market listing, which will be the springboard for significant growth in the year ahead.”
Thorn Medical, led by its chief executive, Jack Kaye, owns a number of healthcare groups focusing on areas such as stem cell research. It is headquartered in the UK and has its research facilities in the Bahamas. The company had already added two more sirs to its board, Sir Eric Peacock and Sir John Lucas-Tooth, ahead of the planned flotation in London, possibly later this month.
Mr Kaye said: [Lord Beaverbrook’s] international medical and technology operations experience will be a great help to achieving our challenging global expansion plans now he has more time to devote to assisting us again.”







